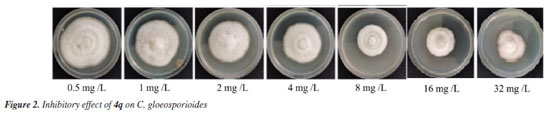

Artigo
| Newly synthesized citral derivatives serve as novel inhibitor of Colletotrichum gloeosporioides: synthesis, inhibitory activity, and mechanism |
|
Wei GaoI,II,III; Xiaoju HuaI,II,III; Hanyue HuangIV; Chen DongI,II,III; Wuxiong WangIV; Haikuan YangI,II,III; Yunyang ChiI,II,III,* I Jiangxi Provincial Key Laboratory of Organic Functional Molecules, Institute of Organic Chemistry, Jiangxi Academy of Forestry, 330101 Nanchang, China Received: 02/12/2025; *e-mail: chiyunyang@jxlky.cn; hulifang0819@163.com Editor handled this article: Nelson H. Morgon We synthesized a series of citral hydrazone derivatives as inhibitors of Colletotrichum gloeosporioides and determined their half-maximal effective concentration (EC50) values. The formylhydrazine (4q) synthesized from citral exhibited the strongest inhibitory effect against Colletotrichum gloeosporioides, with an EC50 value of 1.6548 mg L-1. In addition, after treatment with 4q, the conductivity of C. gloeosporioides treatment solution increased with the increasing concentration, while the soluble protein and reducing sugar contents decreased as the treatment concentration increased. Molecular docking studies showed that the binding of 4q to chitin synthetase was primarily driven by hydrogen bonds and hydrophobic interactions. The binding of 4q to succinate dehydrogenase, on the other hand, was mainly driven by three hydrogen bonds. In summary, this study confirmed a novel inhibitor of C. gloeosporioides, which is expected to be developed into a new antifungal drug, promoting the healthy development of the Camellia oleifera industry. INTRODUCTION Camellia oleifera is a unique high-quality edible oil plant in China.1 However, the growth of C. oleifera has been influenced by a variety of diseases. Among them, Colletotrichum gloeosporioides is one of the primary etiological agents responsible for anthracnose in C. oleifera. Currently, scientists are attempting to use plant-based insecticides to inhibit C. gloeosporioides.2 Up to now, there have been many reports on the use of plant source pesticides for C. oleifera diseases. Zhou3 screened a large number of plant extracts that could effectively inhibit major diseases of C. oleifera, and then initially developed plant-derived agents that could prevent and control the major diseases of C. oleifera. Ai4 screened the crude extracts from 13 kinds of antibacterial plants for effective prevention and controlling of major diseases of C. oleifera. Shi2 found that the fruit and the bark of Maplewood with a concentration of 5 mg mL-1 had a strong antibacterial effect on C. gloeosporioides. Wang and co-workers5 studied the antibacterial activity of natural citral and its derivatives against C. gloeosporioides, and found that natural citral derivatives, citronitrile, neroli and citral 1,2-propylene glycol acetal, were compounds worthy of development for inhibiting C. gloeosporioides. However, these works are still in the exploratory stage of theoretical research, and the special control technology of pathogenic fungi in C. oleifera has not been formed. Citral has been commonly considered to be a promising antimicrobial plant essential oil due to the strong antibacterial and antifungal activities.6-9 However, compared with commercially available fungicides, citral still has the disadvantages of low antibacterial activity and low chemical stability. Thus, citral has been converted into a series of derivatives in recent years by chemists in order to afford compounds with better biological activity.10-12 Acylhydrazone is a kind of Schiff base compound. Compared to most Schiff base compounds, acylhydrazone compounds have more stable chemical properties because their acylhydrazone structure can form stable p-π conjugation, and some groups having strong ability to coordinate with metals, which could form metal complexes with various metals. In recent years, multiple studies13-17 have shown that acylhydrazone compounds have various biological activities such as insecticidal, bactericidal, and anti-tumor properties, and are widely used in fields such as pesticides and pharmaceuticals. Therefore, we want to use citral to synthesize acylhydrazone compounds for screening compounds with high activity against C. gloeosporioides, in order to improve the utilization rate of camphor tree essential oil and promote the healthy development of the C. oleifera industry.
EXPERIMENTAL Synthesis steps of citral hydrazone derivatives In a 25 mL round-bottom flask, different acylhydrazines (1.0 equiv.), citronellal (1.2 equiv.), and 5 mL of methanol were added, and the reaction was carried out at 40 °C for 0.5-2 h to screen the synthetic solvents. The progress was monitored by thin-layer chromatography (TLC) until the reaction was complete. After the reaction was complete, the system was cooled to room temperature, ethyl acetate was added, the solvent was evaporated under reduced pressure, and the residue was purified by column chromatography (petroleum ether:ethyl acetate = 5:1). Determination of antifungal activity of citral hydrazone derivatives against C. gloeosporioides Using the toxic medium growth rate method, a 5 mm diameter punch was used to remove the edges of relatively consistent colonies that had grown in a light incubator for 6 days. The colonies were inoculated onto toxic culture plates treated with different agents, and each treatment was repeated 3 times. The plates were then inverted and cultured in a 25 °C light incubator. After 7 days, the colony growth diameter was measured using the cross method, with sterile water added as the control medium, and the antibacterial rates of various chemical agents were calculated.  where d1 is the colony diameter in the control plate (5 mm), d2 is the colony diameter in the plate with added chemical agents (5 mm). Molecular docking Protein preprocessing The crystal structures of the corresponding proteins were obtained from the RCSB PDB database: chitin synthase (PDB ID: 6RT8, chain A), phospholipase C (PDB ID: 1AH7), and laccase (PDB ID: 3DIV). The crystal structure of succinate dehydrogenase was predicted by AlphaFold 3 (Google DeepMind and Isomorphic Labs, UK). The obtained protein crystals were processed using the Protein Preparation Wizard module in Schrödinger Maestro (version 2023-1, Schrödinger, USA). The processing steps included protein preprocess, regeneration of native states, optimization of H-bond assignment, protein energy minimization, and removal of waters. Ligand preprocessing Using the LigPrep module in Schrödinger, pretreatment was carried out under the OPLS4 force field and a PH value of 7.0 ± 2 to process the 2D SDF structure file of the compound, generating all its 3D chiral conformations, including energy minimization treatment. Active site identification The optimal binding sites were first predicted using the SiteMap module in Schrödinger, and then the Receptor Grid Generation module in Schrödinger was used to set the most appropriate enclosing box (by default, the side length of the inner box is 10 Å and that of the outer box is 30 Å) and manually adjust the mesh frame to perfectly enclose the predicted binding sites. Molecular docking Molecular docking is carried out using the Glide module in Schrodinger. The processed ligand compounds were docked with the active sites of the proteins (using the highest precision XP docking). A lower docking score indicated a lower binding free energy of the compound with the protein, implying higher binding stability. MM-GBSA analysis The molecular mechanics-generalized born surface area (MM-GBSA) calculation of the compound is performed using the Prime module in Schrodinger. MM-GBSA dG Bind was used to approximate the binding free energy between the small molecules and the proteins. A lower binding free energy indicated a higher stability of the ligand-protein interaction. Mycelial morphology of the pathogen Under sterile conditions, a 6 mm puncher was used to cut agar discs with similar growth from the edge of the tested fungal colonies, which were then inoculated into PDA (potato dextrose agar) plates containing a series of compound concentrations (0.5, 1.0, 2.0, 4.0, 8.0, 16.0, 32.0 mg L-1). Each treatment had three replicates, and PDA plates without the compound were used as a control. After 6 days of incubation, mycelia from the edges of the colonies were selected and observed under a microscope to examine changes in mycelial morphology. Cell membrane permeability test The fungi were cultured on PDA medium for 7 days, and a 6 mm diameter fungal disc was taken and placed into a flask containing 200 mL of PDA medium. The culture was incubated for 7 days (28 °C, 180 rpm). Under sterile conditions, the mycelial mat was removed, washed three times with sterile deionized water, and then filtered using a Buchner funnel to collect the mycelium. Electrical conductivity measurement It was weighed 1 g of mycelium and placed it into a flask containing 100 mL of sterile deionized water. The compound was added to achieve a series of concentrations (0.5, 1.0, 2.0, 4.0, 8.0, 16.0, 32.0 mg L-1). Sterile deionized water with solvent was used as the control. Each treatment was repeated three times and incubated on a shaker (28 °C, 180 rpm). At room temperature, electrical conductivity (Mettler Toledo SevenExcellenceT Conductivity Meter) was measured at 0, 30, 60, 90, and 120 min. The conductivity increase for each treatment over time was calculated using the Equation 2.  Measurement of soluble protein content Enzyme solution preparation It was weighed 5 g of mycelium and suspended it in a flask containing 100 mL of PD medium. The compound 4q was added to achieve a series of concentrations (0.5, 1.0, 2.0, 4.0, 8.0, 16.0, 32.0 mg L-1), with sterile deionized water and solvent as the control. Each treatment was repeated three times. After 12 h of treatment, under sterile conditions, the mycelium was removed and washed twice with phosphate buffer (0.2 mol L-1, pH 7.5), then filtered using a Buchner funnel. It was weighed 0.5 g of mycelium, transferred it to a mortar containing 2 mL of phosphate buffer, and it was ground it into a paste on ice. Phosphate buffer was added to make the total volume of 10 mL. Then, it was centrifuged at 12,000 rpm for 15 min at 4 °C and the supernatant was collected for further use. Measurement of soluble protein content The soluble protein content was determined using the Coomassie Brilliant Blue method. One milliliter of the enzyme solution was transferred to a 10 mL centrifuge tube, and 5 mL of Coomassie Brilliant Blue was added. The mixture was shaken and allowed to stand for 5 min. A blank control was prepared by using 1 mL of distilled water and 5 mL of Coomassie Brilliant Blue. The absorbance was measured at 595 nm, with each treatment repeated three times. The protein content (mg g-1) in the sample was determined using the standard curve, and it was calculated using the Equation 3:  where C is the protein content obtained from the standard curve (μg g-1); Vt is the total volume of the extract (mL); Vs is the volume of the sample added for measurement (mL); WF is the fresh weight of the sample (g). Measurement of reducing sugar content by DNS method One milliliter of the prepared enzyme solution was taken, with deionized water used as a blank control. Then, 2 mL of DNS (3,5-dinitrosalicylic acid) reagent was added to the sample. The mixture was heated in boiling water for 5 min. After heating, the test tube was immediately immersed in cold water and allowed to cool to room temperature. Subsequently, deionized water was added to the mixture to bring the volume to 10 mL. The absorbance at 540 nm (D540 nm) was measured and recorded. The measurement was repeated three times, and the average value was taken.  where a is the reducing sugar content calculated based on the standard curve (mg g-1); Vt is the total volume of extract (mL); V is the measurement of liquid volume (mL); m is the sample mass (g).
RESULTS AND DISCUSSION Synthesis of citral hydrazone derivatives Synthesis method design Using citral as the starting material, citronellal was prepared through selective hydrogenation with a nickel catalyst. Based on the presence of the aldehyde group in the chemical structure of citronellal, acylhydrazone derivatives were then synthesized (Figure 1).

Optimization of synthesis conditions Different solvents (dichloromethane (DCM), tetrahydrofuran (THF), MeOH, EtOH, and other solvents with varying polarities) were screened for the synthesis reaction, and the reaction temperature and reaction time were also optimized (Table 1).

By comparing the screened reaction solvents, solvents such as DMSO (dimethyl sulfoxide) and chloroform gave lower reaction yields. However, when protonic solvents like methanol and ethanol were used, the synthesis reaction achieved better yields. Further optimization of the reaction temperature and time showed that when methanol was used as the solvent, at a temperature of 40 °C and a reaction time of 2 h, the reaction yield reached 89%. Substrate expansion in the synthesis of citral hydrazone derivatives Based on the screened reaction conditions, substrate expansion was carried out, and the synthesis of 20 types of acylhydrazone derivatives based on citronellal was performed, yielding the target acylhydrazone compounds (Table 2). The results showed that, when using benzoylhydrazine as the reagent, the reaction yields were all above 60%, while other acylhydrazine reagents gave reaction yields of less than 60%. For example, 1-naphthylacetohydrazine (4p, 43%), formylhydrazine (4q, 32%), acetohydrazine (4r, 53%), pyridine-4-carbaldehyde hydrazine (4s, 32%), and cyanoacetohydrazine (4t, 52%). When the substituent on the benzene ring of the benzoylhydrazine reagent was a simple methyl group, the reaction yields were 78 and 76%, respectively, such as in 4-methylbenzoylhydrazine (4b) and 3-methylbenzoylhydrazine (4c). However, when the substituent was a tert-butyl group (4d), the yield of the product decreased to 61%.
When the benzene ring of benzoylhydrazine contained electron-withdrawing substituents, the reaction yields were generally higher than those with electron-donating substituents. For benzoylhydrazine reagents, the presence of electron-withdrawing groups such as F, Br, or Cl on the benzene ring resulted in relatively high reaction yields. For example, 2-fluorobenzoylhydrazine (4e) and 4-fluorobenzoylhydrazine (4f) showed high reaction yields of 84 and 85%, respectively, while 3-fluorobenzoylhydrazine (4g) yielded 69%. Similarly, reactions involving brominated or chlorinated benzoylhydrazine compounds also gave good yields. For instance, 4-bromobenzoylhydrazine (4i, 74%), 3-bromobenzoylhydrazine (4j, 82%), 4-chlorobenzoylhydrazine (4k, 73%), and 3-chlorobenzoylhydrazine (4l, 77%), all achieved favorable yields. When the benzene ring of benzoylhydrazine contained electron-donating substituents, the reaction yielded the product in moderate yields. The amino-substituted benzoylhydrazine compound (4m) gave the target product with a yield of 63%, while 3-methoxybenzoylhydrazine (4n) and 4-methoxybenzoylhydrazine (4o) gave reaction yields of 63 and 66%, respectively. However, 2-methoxybenzoylhydrazine did not react with antibacterial to form the target acylhydrazone compound, likely due to the steric hindrance at the ortho position. When the substituent was OH, the reaction did not yield the target compound. In this study, 2-methylbenzoylhydrazine and nitro-substituted benzoylhydrazine also failed to react with citronellal to form the target hydrazone compounds. These results indicated that when preparing acylhydrazone derivatives from benzoylhydrazine compounds and citronellal, electron-donating substituents such as CH3 and OCH3 at the 2-position could not yield the corresponding target products, and nitro-substituted acylhydrazine compounds also failed to produce the desired products. Furthermore, the yields of 4d and 4h were found to be lower than those of 4b, 4c, 4e, 4f, and 4g, suggesting that both strong electron-donating and electron-withdrawing substituents were not suitable for this reaction. Structural characterization of citral hydrazone derivatives The structure of the citronellal acylhydrazone derivatives was characterized using 1H NMR, 13C NMR, and ESI-MS, and the characterization data were provided. Taking compound 4a as an example, the 1H NMR spectrum showed a signal for the active hydrogen (N-H) at a chemical shift of 10.9 ppm, and the signals between 7.86-7.30 ppm represented the five hydrogens on the benzene ring and one hydrogen on the alkene group, while the remaining signals corresponded to the chemical shifts of methyl and methylene protons. The 13C NMR spectrum showed signals between 164.2-124.3 ppm, which corresponded to the carbons on the aromatic ring, and between 39.5-17.6 ppm, which corresponded to the aliphatic carbons. The high-resolution mass spectrum showed a theoretical value of 272.1889, with the detected value being 272.1893. The above analysis indicated that the characterization data of compound 4a were consistent with its structure. Similar patterns were observed for other derivatives. This confirmed that the citronellal acylhydrazone derivatives had been successfully synthesized in this study. Antifungal activity of citral hydrazone derivatives against C. gloeosporioides By measuring the antifungal activity of 20 citral hydrazone derivatives against C. gloeosporioides, the half-maximal effective concentration (EC50) values of these derivatives ranged from 1.6548 to 9.1611 mg L-1 (Table 3). Among them, compound 4q exhibited the strongest inhibitory effect against C. gloeosporioides, with an EC50 value of 1.6548 mg L-1. This pronounced efficacy suggests that specific structural modifications in the hydrazone scaffold critically influence interactions with fungal targets.

Mechanism of inhibition of C. gloeosporioides by 4q Effects of 4q on mycelial growth of C. gloeosporioides As shown in Figure 2, 4q exhibited a significant inhibitory effect on C. gloeosporioides, with the colony diameter decreasing as the concentration of 4q increased.
Effect of 4q on the cell membrane permeability of C. gloeosporioides As shown in Figure 3, the conductivity increased with the prolongation of the treatment time, and the increase in conductivity was more pronounced as the concentration of compound 4q increased.

The cell membrane of the microorganism acted as a protective barrier, regulating and selecting the substances that entered and exited. Increased membrane permeability was one of the main manifestations of cell membrane damage. After the cell membrane was damaged, its permeability increased, impairing the selective transport of nutrients and metabolic products in and out of the cell. This led to the leakage of intracellular contents, causing the loss of essential nutrients required for normal growth, disrupting metabolic pathways, and ultimately forcing the microorganism to die.18 Studies by Odds et al.19 and Carson et al.20 indicated that antimicrobial substances acting on the cell membrane could increase its permeability, causing the leakage of intracellular contents such as proteins, nucleic acids, reducing sugars, and metal ions like Na+ and K+. In this experiment, after treatment with compound 4q, the conductivity of the C. gloeosporioides bacterial cell suspension gradually increased with the extension of treatment time. Additionally, as the concentration of compound 4q increased, the increase in conductivity was more pronounced. Wang et al.21 studied the inhibitory effect of tea polyphenols on Magnaporthe oryzae and found that tea polyphenols increased the permeability of the fungal cell membrane, thereby damaging the membrane structure and causing it to lose its protective barrier, thus achieving the purpose of inhibiting the fungus. It was therefore hypothesized that the antifungal activity of phenolic compounds against C. gloeosporioides was due to their damage or disruption of the fungal cell membrane structure, leading to the leakage of intracellular contents and ultimately resulting in cell death. However, the specific site of action still requires further investigation. Effect of 4q on the soluble protein and reducing sugar content of C. gloeosporioides As shown in Table 4, after 12 h of treatment with 4q, the soluble protein content in C. gloeosporioides decreased as the concentration of the compound decreased.

As shown in Table 5, after treatment with 4q, the reducing sugar content in C. gloeosporioides decreased as the concentration of the compound increased.

Peng et al.,22 in their study on the antifungal mechanism of Aster tataricus extract against Penicillium italicum, found that the extract could reduce the total sugar and soluble protein content in the mycelium of P. italicum. Proteins were one of the main components that make up the cell membrane and were essential substances required for the mycelium to maintain its life activities.23 A reduction in protein content within the fungal cells would affect the growth of the mycelium. After treatment with carvacrol, eugenol, and isoeugenol, the soluble protein content in the mycelium of Colletotrichum camelliae decreased as the concentration of the treatment solution increased. Zhou et al.24 found that the extract of cinnamon twig exhibited an inhibitory effect on Aspergillus flavus. By measuring changes in conductivity, soluble protein, and total sugar content, they investigated the antifungal mechanism. The results indicated that after treatment with the cinnamon twig extract, both the soluble protein and soluble sugar content in the mycelium of Aspergillus flavus decreased.25 Reducing sugars were one of the main energy sources for fungal cells, serving as the energy supply and material foundation needed to maintain the normal physiological metabolism of the pathogenic fungus. The utilization rate of reducing sugars directly affected the growth and reproduction of the mycelium.25,26 In this study, after treatment with C. gloeosporioides, the reducing sugar content within the cells decreased, and the content declined as the concentration of compound 4q increased. This indicated that the terpenoid compounds promoted the breakdown of reducing sugars within the fungal cells, causing the loss of energy sources and disrupting the physiological metabolism of the fungus, ultimately leading to cell death. Molecular docking To obtain a better comprehension of the mutual effects between 4q and chitin synthetase (PDB ID: 6RT8, chain A), phospholipase C (PDB ID: 1AH7), laccase (PDB ID: 3DIV) and succinate dehydrogenase, molecular docking was performed using the AutoDock tool (v. 1.5.6, The Scripps Research Institute, USA). Of all conformations, the one with the lowest free energy was considered the most active optimal conformation. As shown in Figure 4a, 4q penetrated into the active pocket of chitin synthetase, where the protein residues LEU15, TYR18, ILE268, LEU86, ALA82, and others formed hydrophobic interactions with 4q. As depicted in Figure 4b, the ligand formed a hydrogen bond with the protein residue ASN221. Therefore, it can be concluded that compound 4q predicted some inhibitory activity against chitin synthetase. As presented in Figure 5a, 4q bound to the surface of the active pocket of phospholipase C, where the protein residues PHE66 and TRP1 formed hydrophobic interactions with 4q. As observed in Figure 5b, the ligand formed a hydrogen bond with the protein residue ALA3. Therefore, it can be concluded that compound 4q predicted poor inhibitory activity against phospholipase C. In Figure 6a, 4q bound to the surface of the active pocket of laccase, where the protein residues PHE404, PRO314, LEU442, and others formed hydrophobic interactions with 4q. As shown in Figure 6b, the ligand formed hydrogen bonds with the protein residues ASN444 and HIE402. Therefore, it can be concluded that compound 4q predicted relatively poor inhibitory activity against laccase. Figures 7a-7b show that 4q penetrated into the active pocket of succinate dehydrogenase, forming hydrogen bonds with the protein residues HIE90, THR262, and THR247. Therefore, it can be concluded that compound 4q formed three hydrogen bonds with succinate dehydrogenase and exhibited competitive inhibition potential against succinate dehydrogenase (SDH) (Table 6). Based on the analysis above, the pronounced inhibitory effect of compound 4q against C. gloeosporioides may be attributed to its dual binding capability to chitin synthase and succinate dehydrogenase, thereby suppressing the enzymatic activities of these two proteins. By inhibiting chitin synthase activity, the compound compromises the integrity of the fungal cell wall, consequently impairing fungal reproduction and survival. Additionally, the suppression of succinate dehydrogenase disrupts fungal respiration, further compromising fungal viability.

Chitin synthetase plays a crucial role in maintaining the structural integrity of the fungal cell wall. It has a significant impact on various aspects of fungi.27 Phospholipase C is involved in cell wall synthesis and also affects intracellular signal transduction, being of vital importance to fungi.28 Laccase participates in the acquisition of nutrients by fungi and influences fungal growth and development.29 For some plant - pathogenic fungi, laccase can help them overcome the defense mechanisms of host plants. Succinate dehydrogenase (SDH) is located on the inner mitochondrial membrane and is an important component of mitochondrial respiratory chain complex II. It occupies a key position in the process of cellular respiration, connecting the tricarboxylic acid (TCA) cycle and the electron transport chain, and influencing fungal respiration.30 These proteins are all potential targets for compounds acting on C. gloeosporioides, the causal agent of anthracnose in C. oleifera.
CONCLUSIONS In summary, in this study, we evaluated a series of citral hydrazone derivatives for predicting the inhibitory activity of C. gloeosporioides and determined their EC50 values. We found that the formylhydrazine (4q) synthesized from citronellal predicted the highest inhibitory activity. After treatment with 4q, the electrical conductivity of the C. gloeosporioides cell fluid increased with the rise in treatment concentration, while the soluble protein and the reducing sugar contents decreased as the treatment concentration increased. Molecular docking studies showed that the binding of 4q to chitin synthase was primarily driven by hydrogen bonding and hydrophobic interactions. The binding of 4q to succinate dehydrogenase was mainly driven by three hydrogen bonds. The compound 4q was expected to improve the utilization rate of camphor tree essential oil, which would contribute to enhancing the overall efficiency and sustainable development of the C. oleifera industry.
SUPPLEMENTARY MATERIAL Supplementary data are available free of charge at http://quimicanova.sbq.org.br, as pdf file.
DATA AVAILABILITY STATEMENT The original contributions presented in this study are included in the article. Further inquiries can be directed to the corresponding authors.
ACKNOWLEDGMENTS This research was funded by the Key R & D Program of Jiangxi Science and Technology Department (20212bbf63046), the synthesis of heterocyclic derivatives and their inhibitory activities against anthracnose of camellia (innovation project 2022:26), the research on the antibacterial activity of essential oil-based derivatives in the PhD startup project of the Jiangxi Academy of Forestry (2022522701), the Training Program for Academic and Technical Leaders of Major Discipline in Jiangxi Province-Young Talent Project (20212bcj23013), the development and commercialization of the camphor tree essential oil source (i) (2020-05-02), and Key Laboratory Project of Jiangxi Province (NO.2024SSY04091).
AUTHOR CONTRIBUTIONS Wei Gao was responsible for the conceptualization; Xiaoju Hua performed the statistical analysis; Hanyue Huang and Lifang Hu contributed to the methodology; Chen Dong conducted the software; Wuxiong Wang carried out the validation; Haikuan Yang completed the formal analysis; Yunyang Chi was in charge of the writing review and editing.
REFERENCES 1. Yang, S. W.; Liang, K. H.; Sun, Y. J.; Zhang, J. S.; Cao, Y. B.; Zhou, J.; Wang, A. B.; Zhang, L. Y.; Hortic. Plant. J. 2023, 9, 811. [Crossref] 2. Shi, H. G.; Wei, X.; Wang, L. H.; Zhang, Z. L.; Li, G. Y.; Journal of Hubei Engineering University 2016, 36, 25 (in Chinese). 3. Zhou, J. H.; Central South University of Forestry and Technology, 2011 (in Chinese). 4. Ai, Q.; Central South University of Forestry and Technology, 2015 (in Chinese). 5. Guo, Y.; Zhou, Y. H.; Wang, P.; Chen, S. Y.; Fã, G. R.; Wang, Z. D.; Jiangsu Agricultural Sciences 2016, 44, 167. [Crossref] 6. Kamle, M.; Mahato, D. K.; Lee, K. E.; Bajpai, V. K.; Gajurel, P. R.; Gu, K. S.; Kumar, P.; Plants 2019, 8, 150. [Crossref] 7. Ma, H. H.; Zhao, Y.; Lu, Z. J.; Xing, R. L.; Yao, X. M.; Jin, Z. X.; Wang, Y. Y.; Yu, F.; Int. J. Biol. Macromol. 2020, 164, 986. [Crossref] 8. Zheng, S. J.; Jing, G. X.; Wang, X.; Ouyang, Q. L.; Jia, L.; Tao, N. G.; Food Chem. 2015, 178, 76. [Crossref] 9. Ghosh, K.; Pharmacogn. Commun. 2013, 3, 41. [Link] accessed in September 2025 10. Yun, H.; Xiu, W.; Wengui, D.; Guishan, L.; Bo, C.; Fuhou, L.; Fine Chemicals 2021, 38, 640 (in Chinese). [Crossref] 11. Jin, X. X.; Wang, J. T.; Bai, J.; Carbohydr. Res. 2009, 344, 825. [Crossref] 12. Narasimhan, S.; Ravi, S.; Vijayakumar, B.; International Journal of Chemistry and Applications 2011, 3, 229. [Link] accessed in September 2025 13. Lei, Y.; Zhang, B.; Zhang, Y.; Dai, X. W.; Duan, Y. L.; Mao, Q.; Gao, J.; Yang, Y. W.; Bao, Z. Y.; Fu, X. F.; Ping, K. Q.; Yan, C. D.; Mou, Y. H.; Wang, S. J.; Eur. J. Med. Chem. 2021, 220, 113437. [Crossref] 14. Kumari, N.; Kaul, A.; Deepika; Srivastava, K.; Mishra, G.; Bhagat, S.; Singh, V. K.; Tiwari, A. K.; Bioorg. Chem. 2022, 121, 105678. [Crossref] 15. Targanski, S. K.; Sousa, J. R.; de Pádua, G. M. S.; de Sousa, J. M.; Vieira, L. C. C.; Soares, M. A.; Pest Manage. Sci. 2021, 77, 325. [Crossref] 16. Yi, M. Y.; You, Y.; Zhang, Y. R.; Wu, G. C.; Karrar, E.; Zhang, L.; Zhang, H.; Jin, Q. Z.; Wang, X. G.; Molecules 2023, 28, 672. [Crossref] 17. Mazumder, L. J.; Kalita, A. J.; Rohman, S. S.; Kashyap, C.; Ullah, S. S.; Baruah, I.; Boro, A.; Guha, A. K.; Sharma, P. K.; ACS Omega 2021, 6, 8656. [Crossref] 18. Shen, X.-Q.: Studies of Biological Activity of Syzygium aromaticum (L.) Merr. et Perry Against Phytophthora capsici; MSc Dissertation, Shanxi Agricultural University, Shanxi, China, 2015 (in Chinese). 19. Odds, F. C.; Brown, A. J.; Gow, N. A. R.; Trends Microbiol. 2003, 11, 272. [Crossref] 20. Carson, C. F.; Mee, B. J.; Riley, T. V.; Antimicrob. Agents Chemother. 2002, 46, 1914. [Crossref] 21. Wang, J. L.; Qiu, Y. X.; Fu, J. L.; Natural Product Research and Development 2011, 23, 918 (in Chinese). [Crossref] 22. Peng, X.; Chen, Y. H.; Chen, J. Y.; Acta Phytopathol. Sin. 2017, 47, 398. [Crossref] 23. Lipke, P. N.; J. Fungi 2018, 4, 59. [Crossref] 24. Zhou, M. J.; Wan, C. P.; Chen, J. Y.; Modern Food Science and Technology 2014, 30, 144 (in Chinese). [Link] accessed in September 2025 25. Ma, X. Y.; Wang, G. Z.; Guo, C. J.; Jiangsu Agricultural Sciences 2016, 44, 200 (in Chinese). [Crossref] 26. Liang, Y. Z.; Wei, D. M.; Wang, L.; Jiangsu Agricultural Sciences 2017, 45, 141 (in Chinese). [Crossref] 27. Yang, J. K.; Zhang, K. Q. In Targeting Chitin-Containing Organisms, 1st ed.; Yang, Q.; Fukamizo, T., eds.; Springer Singapore: Singapore, 2019, p. 153. [Link] accessed in September 2025 28. Fang, Y.; Jiang, J.; Ding, H.; Li, X.; Xie, X.; Mol. Plant Pathol. 2023, 24, 1192. [Crossref] 29. Göker, M.; Voglmayr, H.; Riethmüller, A.; Oberwinkler, F.; Fungal Genet. Biol. 2007, 44, 105. [Crossref] 30. Li, S.; Li, X.; Zhang, H.; Wang, Z.; Xu, H.; Bioorg. Med. Chem. 2021, 50, 116476. [Crossref] |
On-line version ISSN 1678-7064 Printed version ISSN 0100-4042
Qu�mica Nova
Publica��es da Sociedade Brasileira de Qu�mica
Caixa Postal: 26037
05513-970 S�o Paulo - SP
Tel/Fax: +55.11.3032.2299/+55.11.3814.3602
Free access